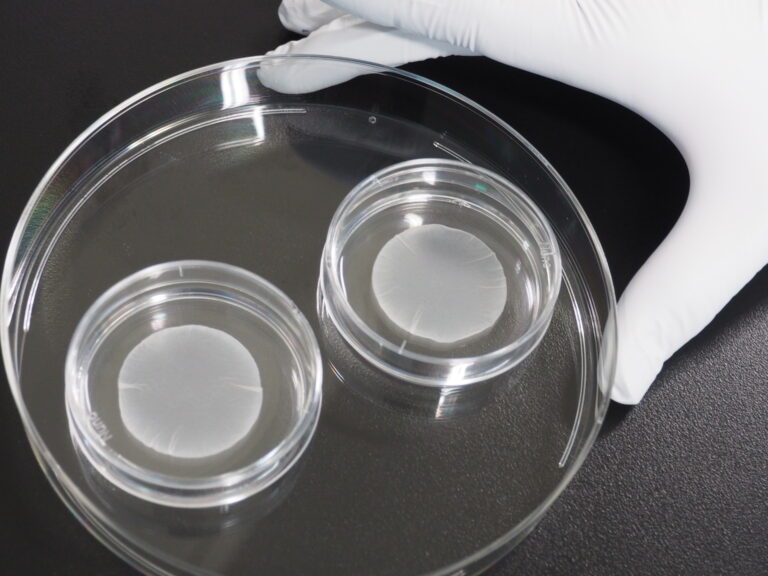

第91回 iPS細胞の市場化が進展
1.はじめに
本年3月、厚生労働省は、iPS細胞を用いた重症心不全とパーキンソン病の治療薬の製造販売を承認した。iPS細胞を用いた再生医療製品として市場化されるのは世界で初めてである。今回はその背景や成果、意義等について分析・考察したい。なお本ニュースレターの読者なら、iPS細胞についての基礎的な説明は不要だとも思われるが、全体像を示すため、筆者の理解している範囲で主要ポイントを簡単に説明したい。
2.本研究を巡る背景
(1)iPS細胞の位置づけ
まず、iPS細胞とその位置づけについて。
iPS細胞は幹細胞(stem cell)の一種である。普通の細胞は、自分と同じ細胞に分裂する自己複製能力しか持たないが、幹細胞は分裂の際に皮膚や血液など別の種類の細胞へ変化する分化能力を併せ持つ細胞である。
幹細胞にはいくつか種類がある。成体内に存在し、限定的な細胞に分化することができる「体性幹細胞(成体幹細胞)」と、特殊な環境で作られ、多様な細胞に分化することができる「多能性幹細胞」がある。
体性幹細胞には体のいろいろな所に存在する。たとえば、血液幹細胞は骨髄などで作られ、赤血球、白血球など血液系のいろいろな細胞に分化していく。また骨幹細胞は骨にあり、軟骨、骨、脂肪細胞などに分化し、骨折を修復する時等に働く。
これに対し、多能性幹細胞は、「ES細胞」と「iPS細胞」がある。
ES細胞(胚性幹細胞:embryonic stem cell)は、マウスで1981年に、またヒトで1998年に初めて樹立された。これは受精卵が発生して胚盤胞という段階になった時に、その内部にある細胞の塊から取り出して培養したものである。ES細胞は、ほとんどあらゆる種類の細胞に分化することができる。このため、組織や臓器を作らせることで、再生医療に役立つことが期待された。だが、ヒトES細胞はヒト胚から作られる細胞であるため、別のヒトに移植すると拒絶反応が起きてしまうという問題がある。また、ヒト胚を壊して作るという倫理問題がある。
そうした問題を克服したのがiPS細胞だった。これは体細胞、すなわち皮膚など、既に分化した細胞から人工的に作られる。そのような分化した細胞に外部から特別な遺伝子を加える等、加工することでES細胞と同様に、さまざまな細胞に分化する性質を持つようになる。このため、人工的に作った多能性幹細胞ということでiPS細胞(induced pluripotent stem cell)と呼ばれる。iPS細胞は京都大学の山中博士により2006年にマウスで、また翌2007年にはヒトで初めて樹立され、同博士はその功績により2012年にノーベル生理学・医学賞を受賞した。iPS細胞はES細胞に比べ、自分の細胞から作ることで、拒絶反応の問題はなかった。また、ES細胞のように胚を壊さなくてもいいため、その点での倫理問題もなく、実用化への期待は高まった。

(2)iPS細胞の市場化に際しての技術上の問題
上記の理由により、iPS細胞は当初より、疾病の克服に対する利用が大きく期待されていた。だが、実際にはiPS細胞の初めての樹立から今回の市場化に至るまで、実に20年近くの歳月がかかった。それには以下のような問題点があった。
①安全性
市場化に際しては、何よりも安全性が重視される。そのためには、iPS細胞を適切な方法で樹立し、また、それから分化させて作った細胞や組織も安全性に問題のないものにする必要があった。
まず、iPS細胞を樹立する方法であるが、当初、山中博士が行ったのは皮膚由来の細胞に4つの遺伝子(Oct3/4、Sox2、Klf4、c-Myc)を直接導入する方法だった。しかしこの方法だと導入された遺伝子は受け手となる細胞内のDNAにランダムに組み込まれる。そうなると、組み込まれる場所によっては受け手側の遺伝子を傷つけたり、異常な遺伝子発現が起こったりする可能性があった。このため、そのようなことが起こらないよう、作出されたiPS細胞を慎重に検査をする必要があった。なお、そもそもそうした危険を避けるため、遺伝子が組み込まれない方法として、メッセンジャーRNAやタンパク質を導入する方法も開発されてきたが、これは遺伝子導入よりさらに樹立が難しかった。
また、樹立されたiPS細胞から目的とする組織や器官に分化させる方法であるが、これはそれぞれ、目的の組織や器官になるよう、適切な化学物質、成長因子などを導入することによって行われる。その際、分化させた細胞の中にもともと別の種類の細胞が混ざったり、分化の過程で別の組織や器官に分化していったりして、移植後にがんやテラトーマ(奇形種)が生じる可能性があった。このためそうならないよう慎重に検査する必要があった。
➁迅速性・コスト
次に、市場化にとって課題となるのは、迅速性やコスト面である。
患者自身の細胞からiPS細胞を樹立し、それを目的に合った組織や器官に分化させ、移植に必要な量まで増やし、さらに正しく分化したかどうかを見極めるには、半年にも及ぶ工程が必要となる。これでは、たとえば脊髄損傷のように、損傷後すぐに移植をしなければ手遅れになってしまうような疾患や事故には間に合わない。また、このような過程で一人一人の患者に合ったiPS細胞やその分化組織・器官をオーダーメイドで調達するには膨大なコストや労力を費やさねばならず、現実的には多くの患者に適用するのは困難だった。
(3)細胞バンクの発展
こうした問題を一気に克服しようとしたのが細胞バンクだった。これは、患者が来てからiPS細胞やそれからの組織・器官を作出するのではなく、あらかじめ全ての患者に合うようなiPS細胞やそれらからの組織・器官を作出して保管しておくというものだった。すなわち、オーダーメイドではなく、既製品を調達しようという発想だった。
他人の組織や臓器の移植を行ったときに拒絶反応が起こるのは、組織適合抗原(HLA)という、それぞれのヒトによって異なる何十種類もの抗原が存在しているからである。そのうち、大どころである数種類が一致していれば大きな拒絶反応は起こらない。このためドナーを募って、あらゆる患者に適用できるような数十~数百種類の細胞を用意しておくという計画が実施された。
これにより2022年11月の段階では日本人の約40%に適合するHLAの組合わせは確保できたが、それでもHLAの組合せによっては調達ができない場合もあった。
そこで、次に考えられたのは、あらかじめ、拒絶反応を引き起こす主要なHLA遺伝子を取り除き、あらゆるヒトに対応できるようにした細胞を作出しようとするものだった。
(4)法制度の整備
こうしたiPS細胞を用いた治療の市場化を促進するため、日本では2014年、薬事法の改正が行われ、薬機法(医薬品、医療機器等の品質、有効性及び安全性の確保等に関する法律)が制定された。
通常、ヒトに対する医薬品・医療機器の承認には、臨床研究の後、臨床試験(第Ⅰ相~第Ⅲ相)が行われ、その結果、安全性と有効性の確認が全部なされてから承認、市販に至る。しかし、薬機法では、ヒトの細胞に培養等の加工を施した再生医療等の製品では、有効性の確認を行う第Ⅲ相試験が行われていなくても、安全性が確認され、有効性が推定された場合には、当局の判断によって7年以内の販売を条件付きで承認できることとした。
ただし、継続的な承認を得るにはその7年以内に有効性やさらなる安全性を確認する必要があるが、ともかくも日本は、これにより世界に先駆けて迅速な承認を実現することを目指したのである。

)
(5)市場化に向けた進展
こうしてiPS細胞治療は市場化に向けて着実に進展してきた。下の図にもあるように、iPS細胞ストックを用いた臨床試験が行われているものとして、今回市場化されたもののほかに、眼、神経、骨、血液・免疫、肝臓、膵臓、腎臓、がん等があり、市場化に向けて着実に進展してきている。

3.今回の実用化について
本年3月8日、厚生労働省の委員会は、重症心不全とパーキンソン病という2つの疾患に対するiPS細胞を用いた治療について、それぞれ製造販売を承認するよう勧告を行い、それを受けて厚生労働大臣は承認を行った。これにより、iPS細胞を用いた治療法が世界で初めて実用化されることになった。それぞれの内容は以下のとおり。
(1)重症心不全の治療
心不全とは、心臓のポンプ機能が低下した結果、十分な血液を全身に送り出すことができなくなり、酸素や栄養が臓器や細胞に供給不足となり、全身の臓器機能の低下をきたした状態をいう。日本には現在、120万人以上の心不全患者がいるとされている。このうち重症心不全は、心機能の低下が極めて深刻で、通常の心不全治療を行っても回復が得られないような状態になったものを指す。
重症心疾患の患者を対象としたiPS治療は、大阪大学の心臓血管外科医・澤芳樹特任教授が率いる研究グループが京都大学iPS細胞研究所(CiRA)と共同で開発した。iPS細胞を小さなパッチ状に形成し、それを病変のある心臓の表面に貼ると、心筋パッチは収縮を促進すると同時に、血管新生を促進するサイトカインを放出する。
今回製造販売承認を受けたのは、大阪大学発のスタートアップ企業であるクオリプス(CUORiPS)社である。同社製のリハート(RiHEART)と呼ばれるパッチを重症心不全患者8名が装着したところ、深刻な安全性の問題はなく、患者の心機能は改善したと報告されている。
(2)パーキンソン病の治療
パーキンソン病は、神経伝達物質であるドーパミンを作る脳内の神経細胞が減ることによって、手足が震えたり、体が動きにくくなったりする神経の病気である。日本国内に患者が29万人、世界では1,000万人以上いる。これに対しては、脳に直接ドーパミンを補充したり、ドーパミン受容体に刺激を与えることでドーパミンが出たのと同じ状態にしたり、電極を脳に埋め込むという治療法があった。ただ、いずれも効果が持続的ではなく、神経細胞を増やす等の持続的効果のある方法が求められていた。
CiRA現所長の脳神経外科医である高橋淳氏が率いるグループが開発したパーキンソン病治療薬は、パーキンソン病で死滅するドーパミン産生ニューロンをiPS細胞で代替するものである。小規模なパイロット試験では、外科医がパーキンソン病患者6人の頭蓋骨に穴を開け、代替細胞を注入した。安全性の問題はなく、移植後24か月で4人の患者に症状の改善が見られたということで、本ニュースレターで紹介済みである(第70回 パーキンソン病に対する幹細胞治療が進展)。
今回、アムシェプリ(Amchepry)と名付けられたこの治療法について、住友製薬とラクセラ社が申請し、製造販売承認を得た。
4.今後の実用化の展望
今回の成果も含め、体性幹細胞やES細胞等他の幹細胞臨床試験も加えると、幹細胞に基づく再生医療は成熟期を迎えたと言える。現在臨床試験の対象となっているものも、やがては今回の2例のように市場化に移行していくものと思われる。
ただ、将来的にはいくつか課題もある。
上述のように、日本の規制では、臨床試験を行わずに早めに再生医療の実用化を行うことができるようになった。これにより実用化はますます促進されることになる。これに対しては、簡素化された承認プロセスによって、移植された幹細胞がテラトーマ(奇形種)を形成するリスクが見落とされる可能性もあるとの指摘等がある。移植された幹細胞の長期的安定性については、市場化後、どのようなデータが出てくるかは注視しなければならない。
また現段階では、実用化や臨床試験が行われているのは、細胞の集まりとか、薄いシート状のものであり、臓器のような大きな立体的な形状のものは含まれていない。これを作製するには、細胞をインクジェットとして用いた3次元プリンターを使うことも想定されるが、それだと中に含まれる血管や神経までは再生されず、時間が経つと崩れてしまう。
やはり器官や臓器を作るには、胚からの発生・分化のように、周囲の環境が重要だと考えられる。以前、本ニューズレターで紹介したブタ工場、つまりブタの胚にヒトES細胞やiPS細胞を導入して、ブタの体内でヒトの臓器を作るという方法はそのような環境を実現できるものである(第1回 動物臓器のヒトへの移植~世界初のブタ心臓移植のもたらした衝撃)。
だが、やはりヒトの臓器中にブタの血管や神経が混ざってしまうという課題を克服するのは難しい。さらに、それよりも遺伝子組換えによって拒絶反応に関与する遺伝子を除去したブタの臓器を移植するという方が実用化に近いと思われる。
5.おわりに
今回、日本が世界に先駆けてiPS細胞の実用化を達成したのは、予算面、制度面を含め、国がiPS細胞を樹立した山中博士の功績に目を付け、iPS研究に対する支援を強力に行ったことが大きい。iPS細胞に傾斜しすぎだとして、他の幹細胞研究者からの批判があったことも事実であるが、今回の実用化により、日本が強い分野を重点的に支援するということは方向性としては間違っていなかったとも言えそうだ。
ただ、それでも予算や人員的には米国に劣ってはおり、ここでは紹介しなかったが世界的にも実用化に向けたさまざまな臨床試験が行われ、日本は激しく追い上げを受けている。
iPS関係の研究者自体も資金集めやドナー集め等に尽力してきていることを見るにつけ、国と研究者が意見交換しつつ、それぞれの果たせる役割を最大限果たすとともに、協力を行っていくことの大切さを著者としては感じた次第である。
参考文献
・D. Normile (2026) “Stem cell therapies ‘come of age’ with two conditional approvals in Japan”, Science Vol.391, 964-965
・「3種類の幹細胞について、それぞれの特長や未来について解説」国際幹細胞機構HP
https://stemcells.or.jp/chapter3/
・「再生医療とは」(株)ヘリオス HP
https://www.healios.co.jp/regenerative-medicine
・「iPS細胞とは?治せる病気は?実用化するための問題点とSTAP細胞との違いもわかりやすく解説」(2025/9/25)Spaceship Earth HP
https://spaceshipearth.jp/ips/
・「人を笑顔にする」大阪大学名誉教授 澤芳樹HP
https://sawayoshiki.com/
ライフサイエンス振興財団理事兼嘱託研究員 佐藤真輔

